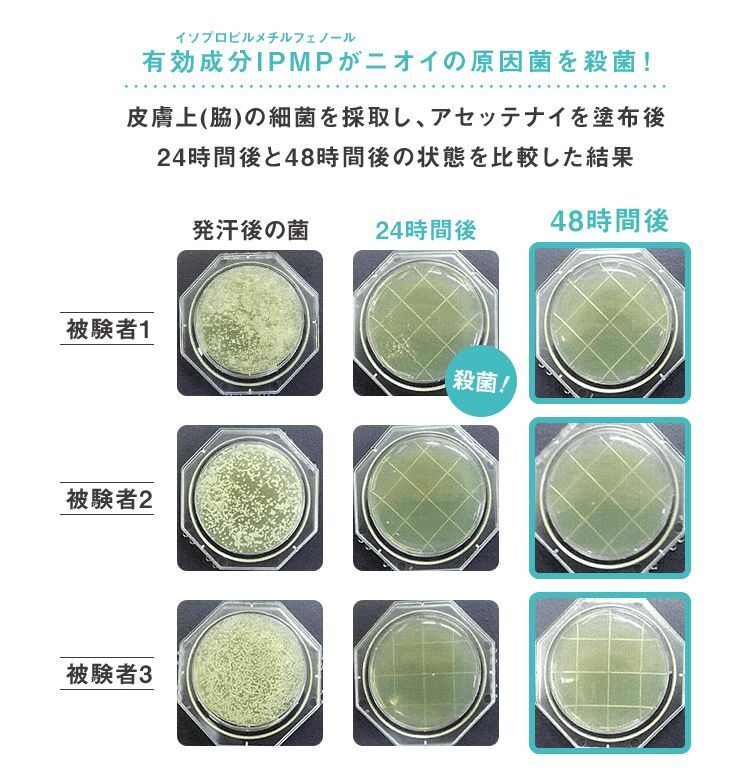

※比較については使用者の意見です

暑くなってきて、汗によるこんなお悩みありませんか?
✔ 汗でマスクが蒸れる/メイクがドロドロ
✔ スマホを持つ手が汗でヌルヌル
✔ 朝セットした髪がすぐにベトベトに
✔ 背中やワキの汗染みが気になる
✔ 1人だけ汗だくで恥かしい
汗に悩む人なら、どれも心当たりがあるはず…
「何をやってもダメだ」と諦めてませんか?

その悩み、
「しょうがない」で済ませないで!
今回は、そんな止まらない汗でお悩みのあなたに、おすすめ商品をご紹介!
この夏、オススメの商品はこちら!
↓↓↓
滝汗に悩むインフルエンサーのぺえが
製薬会社とコラボして本気で開発!


制汗剤とは思えない可愛いフォルムで
既にSNS上で話題沸騰中のAsettenai?
人気雑誌にも多数取り上げられている
みたいなんです!

なぜこんなにも人気なのか…
その秘密は、開発の裏側にありました。
この制汗剤をプロデュースしたのは、
YouTubeなどで大人気のぺえさん!

実はぺえさんも、ずっと汗に悩まされており
滝汗がコンプレックスだったのだそう。。

汗染みが目立ち、SNS上への書き込みは
鬼のリツイート数。
そんなご自身の経験をもとに作ったのが
このAsettenai?だったんです!

特に気になる顔やワキはもちろん、
全身に使えちゃうのが嬉しいポイント♡

本気で汗に悩むぺえさんが、
同じように汗で悩む人のために
とにかく実感にこだわって作ったのだそう!

夏になると、気温の上昇と共に
必然的に増えるイヤな汗…。
それは主に、3種類ある汗のうち
「温熱性発汗」が原因なんです。
温熱性発汗とは、体温を下げるための
汗のことで、全身から持続的に発汗します。

この汗を防ぐためには、
汗をかく前の対策が重要だったんです!
\Asettenai?は、汗の出口を徹底ブロック!/


実は、汗が出る汗腺には
「エクリン線」と「アポクリン腺」の
2種類あることをご存じですか?

汗によるイヤな匂いは、
「アポクリン腺」から出る汗を
皮膚の菌が分解することで発生するもの。。
そこで!
\Asettenai?は匂いの元も徹底ブロック!/
殺菌・防臭作用を持つ成分を配合しており、
しっかり消臭までしてくれるんです♪
し・か・も!
Asettenai?にも香りがついているんですよ♡

まるで香水をつけてるようないい香りが漂い、
モテること間違いなしです。(笑)
注文してすぐに届きました!
中身はこんな感じ。

Asettenai?はペールブルーの箱に入っていました。
制汗剤だなんて思えない可愛い見た目が嬉しい♡
蓋は鏡としても使えそうです!

肝心の使い心地は…
クリームタイプで伸びが良く、
何よりとってもいい香り!!

顔にも使えるみたいなので、
顔汗で悩んでいる方は下地として使っても良さそう!

汗でテカテカしていた手が、こんなにサラサラに!
私は手汗で悩んでいたのですが、
これなら仕事中でも周りを気にせずに使えそう♡

※公式サイトが一番お得です!!
注文が殺到していて在庫数が少なくなっているみたいなので
無くなる前に、早めの購入をオススメします💦


| 初回価格 | 1,480円 |
|---|---|
| 対策部位 | 顔 |
| 実績 | 厚生労働省認可の 顔汗対策用クリーム |
マスク生活が続く中で、顔汗にお困りの方も多いはず。。
そんな顔汗対策に特化したクリームがこのサラフィネ!
初回のお値段もお手頃なので、試しやすいのも嬉しいポイント♪

| 初回価格 | 2,728円 |
|---|---|
| 対策部位 | ワキ |
| 実績 | モンドセレクション受賞 |
こちらは脇汗に特化した制汗剤で、様々な賞を受賞しています。
気になる脇の汗と、そこから発生するニオイ(ワキガ)を徹底除菌してくれます。
満足度は驚異の99%で、ワキガに悩む方にはぜひオススメです!

| 初回価格 | 550円 |
|---|---|
| 対策部位 | 顔 |
| 実績 | 売上個数1,380,000個突破 |
お肌に優しい成分で、顔にも使える制汗クリームを実現!
汗の出口に蓋をするのではなく、汗腺を引き締めるため
お肌の負担を軽減してくれるんです。
3日分のトライアルが550円と、気軽にお試しできるのもポイント♪

| 初回価格 | 490円 |
|---|---|
| 対策部位 | 脇 |
| 実績 | モンドセレクション受賞 |
子どものワキガでお困りの方にも!
お肌に優しい成分を配合しているため、
小さなお子様でも安心して使えるのだそう。
抑臭試験実施済みなので、諦めていたワキガにも期待大です。

いかがだったでしょうか?
おすすめ第一位は、全身に使えて持ち運びも便利な
Asettenai?となりました!
これから夏本番、イヤな汗とはおさらばして
サラすべ肌を手に入れちゃいましょう♡
※比較については使用者の意見です